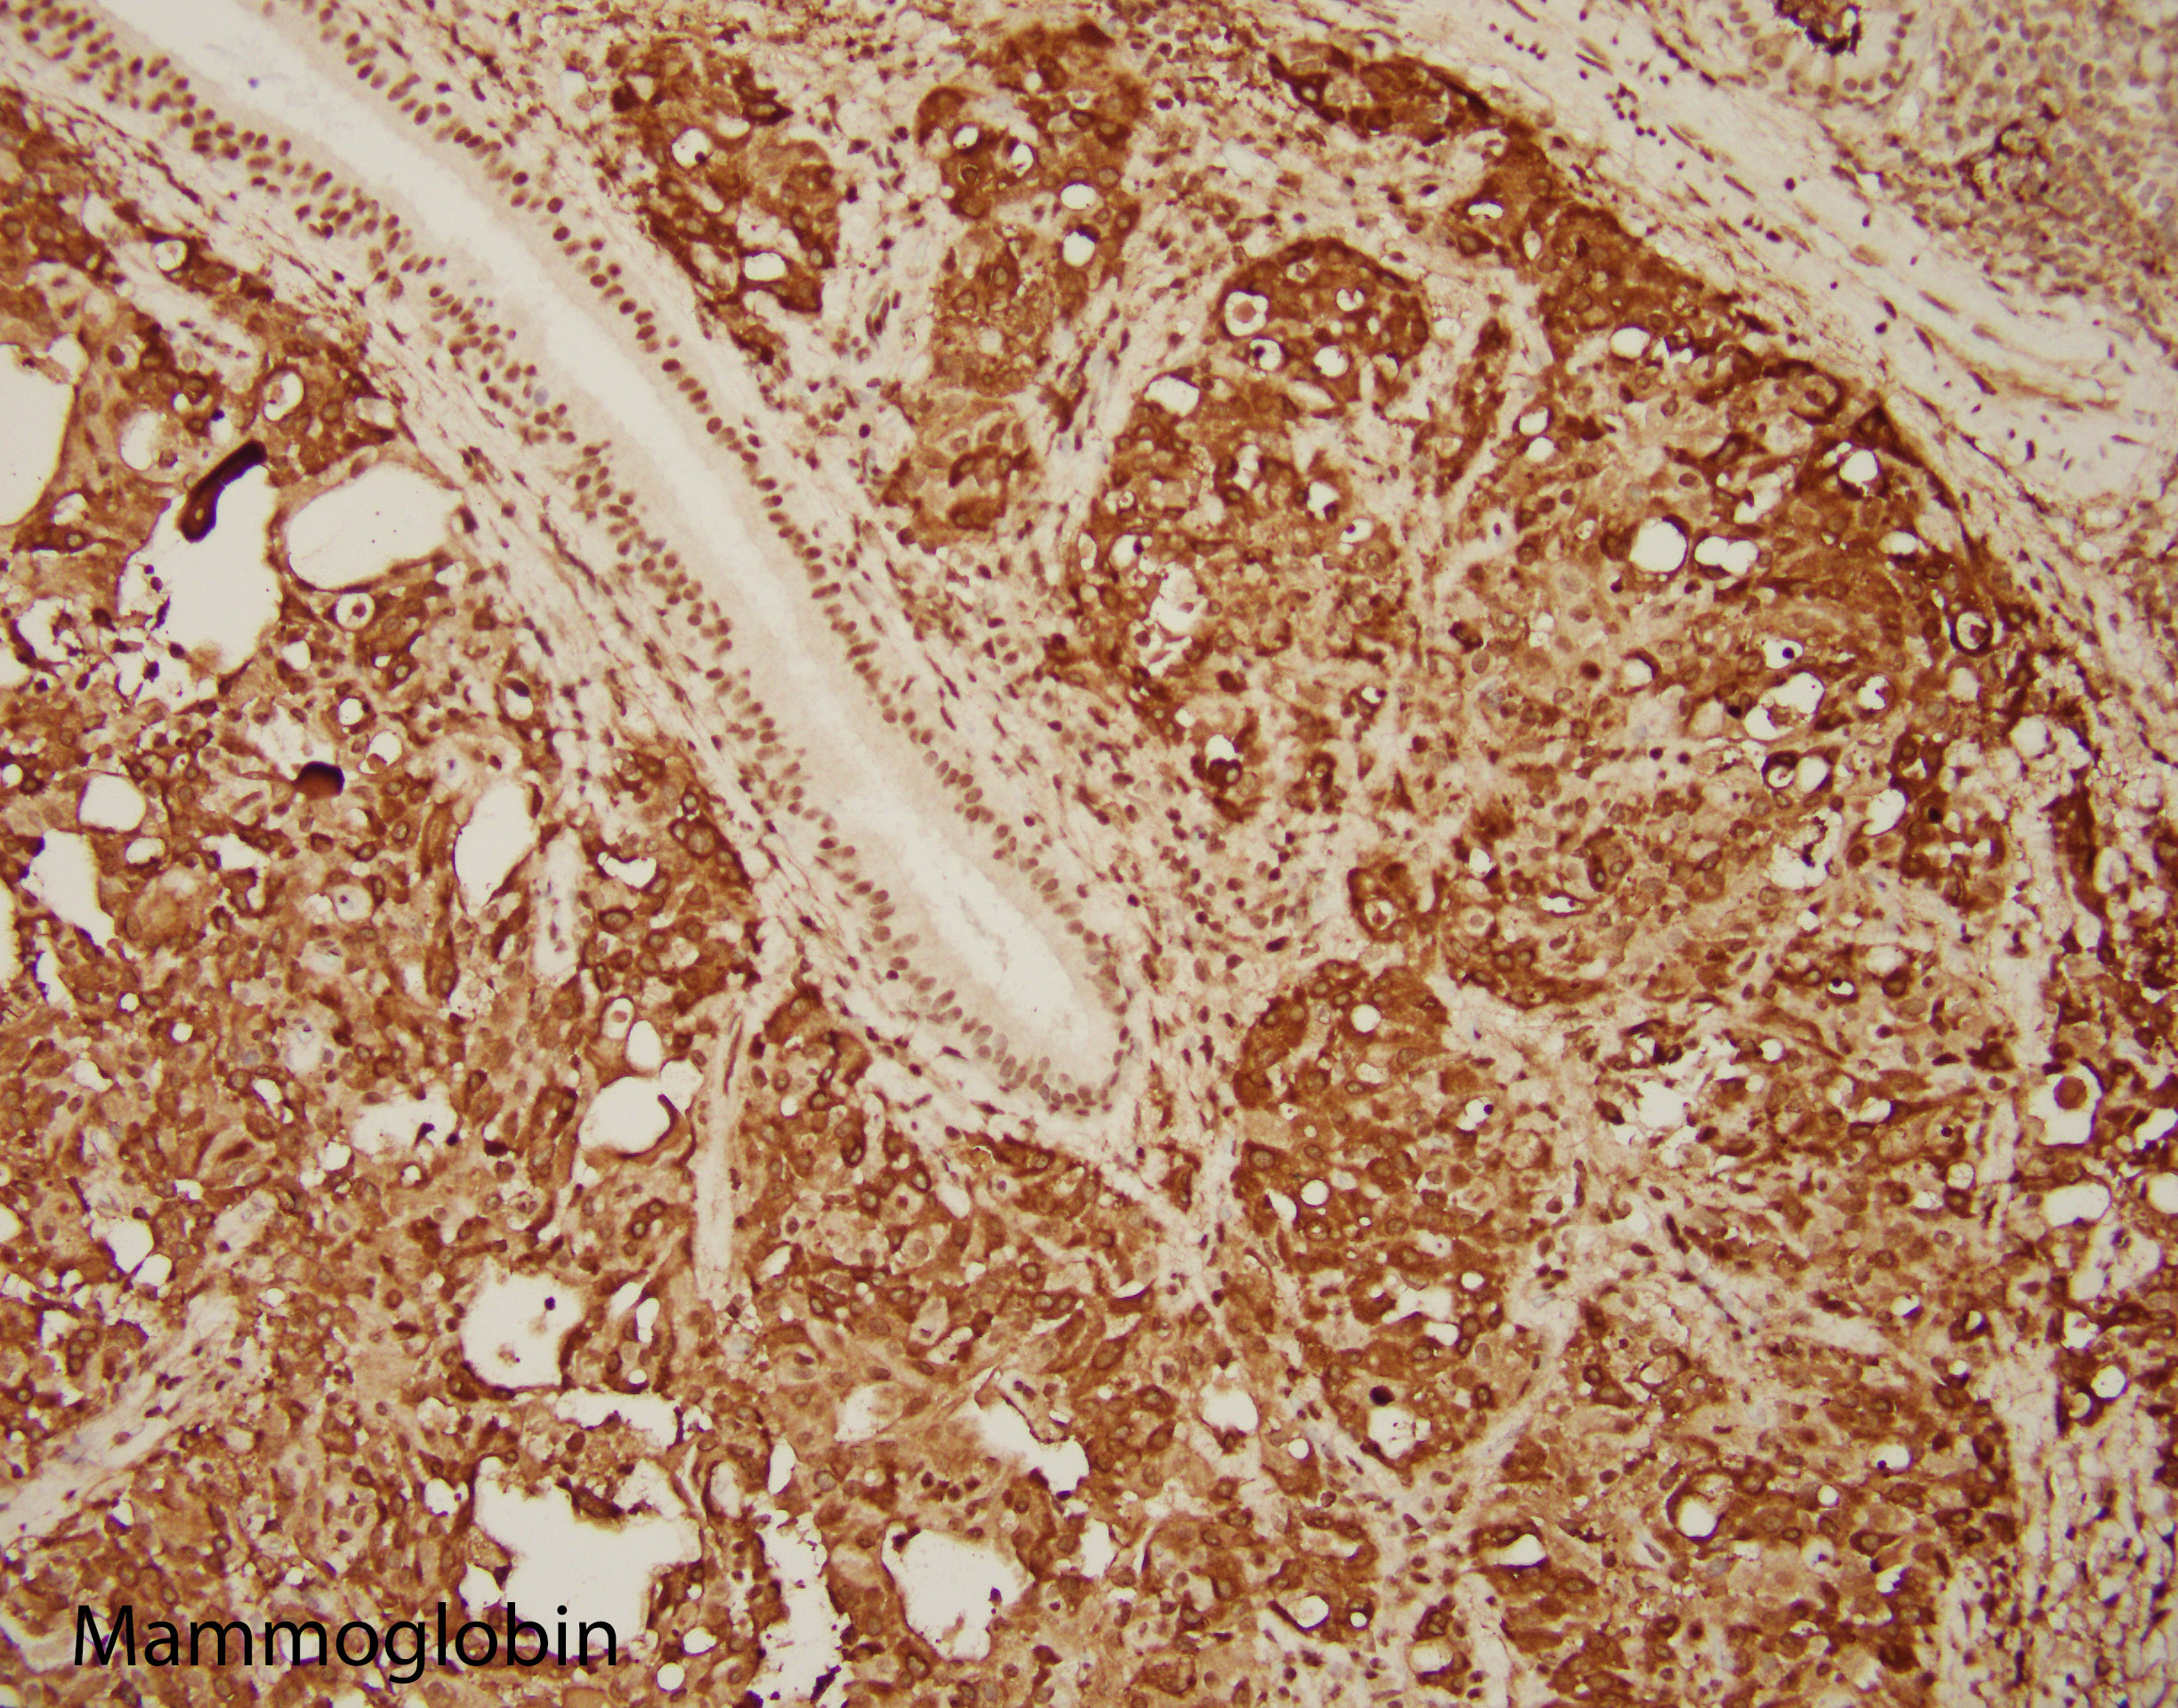
WIN 20201023 14 56 49 Pro

Case History
Patient history:
51-year-old male with a three-week history of 2.5 cm left parotid mass. H&E and IHC are illustrated. P63 and DOG1 were negative.
Which of the following is the correct diagnosis and the typical associated molecular changes?
- Adenoid cystic ca—MYB-NFIB
- MEC—CRTC1-MAML2
- Acinic cell ca—NR4A3
- Secretory ca—ETV6-NTRK3

Correct answer is D
Discussion:
Secretory carcinoma/mammary analogue secretory carcinoma (MASC) is a salivary gland carcinoma with histologic features and molecular changes similar to mammary secretory carcinoma. MASC typically presents as a painless slowly growing parotid mass in a middle age patient with equal sex distribution. Histologically, MASC shows a lobulated or infiltrative lesion composed of cystic, papillary, or tubular structures with luminal secretions. The tumor cells typically exhibit small uniform nuclei with eosinophilic cytoplasm. The differential diagnosis includes acinic cell carcinoma that exhibits PASD positive zymogen cytoplasmic granules, mucoepidermoid carcinoma (MEC) composed of a mixer of cells including intermediate and mucin producing cells and adenoid cystic carcinoma that shows cribriform, tubular, and/or solid with small to medium cells with eosinophilic to clear cytoplasm. MASC is mammaglobin (+), S100 (+), DOG1(-), and p63 (-). Whereas Acinic cell carcinoma is mammaglobin (-) and DOG1(+), Mucoepidermoid carcinoma is p63 and CK5/6 (+), and Adenoid cystic carcinoma is p63 (+) and mammaglobin (-). MASC harbors ETV6-NTRK3 fusion gene resulted from t(12;15)(p13;q25) which has not been detected in other salivary gland neoplasms. MASC is usually indolent tumor, however, lymph node and distant metastases have been reported. Poor prognostic factors include high-grade transformation and high clinical stage at presentation.
Case contributed by: Haider Mejbel, M.D., Fellow, Surgical Pathology